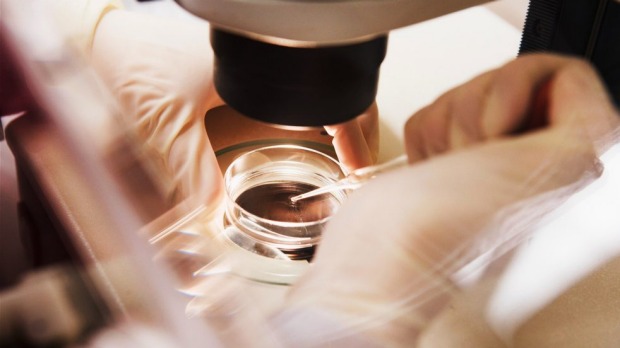

Η Άννα είναι 36 ετών, είναι ελεύθερη και ακόμα δεν έχει βρει τον κατάλληλο σύντροφο. Αισθάνεται ότι το βιολογικό της ρολόι “χτυπάει”, και φοβάται να μην προλάβει να κάνει παιδιά.
Η Μαρία, 35 ετών, είναι διοικητικός στέλεχος σε μια μεγάλη πολυεθνική εταιρεία. Παρά το γεγονός ότι θα ήθελε να έχει μια οικογένεια, πιστεύει πως η μητρότητα αυτή τη στιγμή θα επηρεάσει την καριέρα της.
Και οι δύο γυναίκες αναρωτιούνται το ίδιο: Μήπως να παγώσω τα ωάριά μου;
Η κατάψυξη ωαρίων, ή κρυοσυντήρηση ωαρίων, έχει ξεκινήσει εδώ και αρκετά χρόνια. Αλλά τον τελευταίο καιρό έχει συζητηθεί εκτενώς από τα μέσα ενημέρωσης, ειδικά από τότε που οι εταιρίες Facebook και Apple ανακοίνωσαν πως θα πληρώνουν την κατάψυξη ωαρίων για τις γυναίκες υπαλλήλους τους (διάβασε περισσότερα εδώ).
Πιθανόν να έχεις ακούσει για την κατάψυξη ωαρίων, αλλά πώς είναι η διαδικασία; Είναι ασφαλής; Πότε την κάνουμε; Είναι εγγυημένο το αποτέλεσμα;
Σε αυτό το άρθρο θα περιγράψουμε τη διαδικασία της κατάψυξης ωαρίων και θα συζητήσουμε κάποιες “πραγματικότητες” που πρέπει να γνωρίζεις σε περίπτωση που αποφασίσεις να προχωρήσεις σε αυτό το εγχείρημα…
Τι είναι η κατάψυξη ωαρίων; Πώς γίνεται;
Κατάψυξη ωαρίων σημαίνει ότι τα ωάρια μιας γυναίκας εξάγονται από τις ωοθήκες, καταψύχονται και αποθηκεύονται για μελλοντική χρήση.
Είναι γνωστό πως η γυναικεία γονιμότητα μειώνεται με την ηλικία, και αυτό οφείλεται στη γήρανση των ωοθηκών και των ωαρίων. Σε αντίθεση με τους άνδρες, οι οποίοι παράγουν σπερματοζωάρια κατά το μεγαλύτερο μέρος της ζωής τους, οι γυναίκες γεννιόμαστε ήδη με όλα μας τα ωάρια: έχουμε περίπου 2.000.000 ανώριμα ωάρια στη γέννηση, όταν φτάσουμε στην εφηβεία μένουν περίπου 300.000 και κάθε μήνα χάνουμε αρκετές χιλιάδες. Στα 30 μας έτη το 90% των ωαρίων έχει ήδη φύγει, και μόνο το 3% παραμένει στα 40.
Αλλά δεν είναι μόνο η ποσότητα που έχει σημασία, είναι και η ποιότητα. Καθώς το σώμα γερνάει, γερνάνε και τα ωάρια, το τι σημαίνει ότι το γενετικό τους υλικό μπορεί να αλλοιωθεί. Αυτός είναι ο λόγος που οι γυναίκες μεγαλύτερης ηλικίας έχουν μειωμένη γονιμότητα, αλλά και αυξημένο κίνδυνο αποβολών και να αποκτήσουν ένα μωρό με ορισμένα προβλήματα όπως το σύνδρομο Down.
Σε αντίθεση με τα ωάρια, η μήτρα δεν επηρεάζεται από τη γήρανση και μπορεί υποστηρίξει μια εγκυμοσύνη, ακόμα και στα 50 έτη. Αυτό ισχύει και για γυναίκες σε εμμηνόπαυση.
Συνεπώς, αν παίρνουμε τα ωάρια μιας γυναίκας και τα παγώνουμε, η ποιότητα των ωαρίων θα παραμείνει αμετάβλητη με το χρόνο: ας πούμε ότι παγώνεις τα ωάριά σου όταν είσαι 30 ετών, και τα χρησιμοποιείς στα 40 σου, τα ωάρια θα εξακολουθήσουν να είναι 30 χρονών!
Σε ποιες γυναίκες απευθύνεται η κατάψυξη ωαρίων;
–Γυναίκες που θέλουν να καθυστερήσουν τη μητρότητα για κοινωνικούς λόγους:
συνήθως λόγω εκπαιδευτικών ή επαγγελματικών υποχρεώσεων, ή επειδή δεν είναι σε μια σταθερή σχέση. Αυτός είναι ο πιο συχνός λόγος που οι γυναίκες ζητάνε και πραγματοποιούν την κατάψυξη ωαρίων, αν και οι απόψεις των επιστημονικών εταιρειών διίστανται πάνω σε αυτό το θέμα. Ενώ η Ευρωπαϊκή Εταιρεία Ανθρώπινης Αναπαραγωγής και Εμβρυολογίας (ESHRE) την υποστηρίζει, δηλώνοντας: «η κρυοσυντήρηση ωαρίων θα πρέπει […] να είναι διαθέσιμη και για τις γυναίκες […] που θέλουν να προστατεύσουν τον αναπαραγωγικό τους δυναμικό κατά της απειλής του χρόνου», η Αμερικανική Εταιρεία Αναπαραγωγικής Ιατρικής (ASRM) είναι πιο επιφυλακτική, και συμπεράνει: «Δεν υπάρχουν ακόμα επαρκή στοιχεία που να συνιστούν την κρυοσυντήρηση ωαρίων με μοναδικό σκοπό την παράκαμψη της αναπαραγωγικής γήρανσης».
Αν και η κατάψυξη ωαρίων για κοινωνικούς λόγους (“social egg freezing”) θα είναι το επίκεντρο αυτού του άρθρου, υπάρχουν και άλλες περιπτώσεις στις οποίες η κατάψυξη ωαρίων είναι, πέρα από κάθε αμφιβολία, ανεκτίμητης αξίας:
–Γυναίκες που έχουν διαγνωστεί με ορισμένους καρκίνους.
Μερικές θεραπείες για τον καρκίνο, όπως χημειοθεραπεία, ακτινοθεραπεία ή κάποιες χειρουργικές επεμβάσεις μπορεί να βλάψουν τις ωοθήκες και να οδηγούν σε στειρότητα. Ως εκ τούτου, το πάγωμα των ωαρίων πριν από τη θεραπεία μπορεί να διατηρήσει τη γονιμότητα σε αυτές τις γυναίκες.
–Γυναίκες με υψηλό κίνδυνο πρόωρης εμμηνόπαυσης:
- γυναίκες που έχουν ένα ελαττωματικό γονίδιο ή χρωμόσωμα που είναι γνωστό ότι προκαλούν πρόωρη εμμηνόπαυση,
- άτομα με ισχυρό οικογενειακό ιστορικό πρόωρης εμμηνόπαυσης.
- γυναίκες με ένα ελαττωματικό γονίδιο (όπως BRCA1 και 2) που σχετίζονται με υψηλό κίνδυνο καρκίνου των ωοθηκών, όταν κρίνεται αναγκαία η αφαίρεση των ωοθηκών. Σε αυτές τις γυναίκες, αν η τεκνοποίηση δεν έχει ολοκληρωθεί, η κατάψυξη ωαρίων μπορεί να είναι μια επιλογή πριν από την επέμβαση.
–Ορισμένα ζευγάρια που υποβάλλονται σε εξωσωματική γονιμοποίηση (IVF):
- Όταν για θρησκευτικούς ή νομικούς λόγους, δεν δύναται να καταψυχθούν τα έμβρυα. Αυτό ισχύει και για χώρες όπως η Ιταλία, όπου η κατάψυξη εμβρύων απαγορεύεται από το νόμο.
- Αν ο άνδρας αδυνατεί να συλλέγει σπέρμα, ή όταν άνδρες με σοβαρή υπογονιμότητα δεν έχουν επαρκή αριθμό σπερματοζωαρίων να γονιμοποιήσουν όλες τα διαθέσιμα ωάρια. Σε τέτοιες περιπτώσεις, τα ωάρια μπορούν να καταψυχθούν για χρήση σε μεταγενέστερη ημερομηνία.
Πώς είναι η διαδικασία που θα πρέπει να ακολουθήσω για να παγώσω τα ωάριά μου;
Για να γίνει η κατάψυξη ωαρίων, η γυναίκα θα πρέπει να υποβάλλεται σε μια ορμονική θεραπεία, με στόχο να διεγείρει τις ωοθήκες να παράγουν πολλαπλά ωάρια. Υπάρχουν διάφορα πρωτόκολλα για αυτό -τα λεγόμενα βραχύ και μακρύ πρωτόκολλα- ανάλογα με την ωοθηκική λειτουργία και το πόσο επείγουσα είναι η διαδικασία (π.χ. όταν η κατάψυξη ωαρίων γίνεται πριν από τη θεραπεία του καρκίνου).
Αρχικά, χορηγείται ένα φάρμακο για την αναστολή των φυσικών ορμονών της γυναίκας, μερικές φορές σε συνδυασμό με αντισυλληπτικά χάπια. Στη συνέχεια, ακολουθείται μια ορμονική θεραπεία σε ενέσιμη μορφή -οι ενέσεις συνήθως τις κάνει η ίδια η γυναίκα- για 10 έως 14 ημέρες μέχρι να ωριμάσουν τα ωάρια.
Όταν τα ωάρια είναι ώριμα, αναρροφούνται με μια βελόνα διαμέσου του κόλπου, με υπερηχογραφική καθοδήγηση. Η διαδικασία γίνεται συνήθως κάτω από ήπια αναισθησία (“μέθη”). Τα αυγά καταψύχονται αμέσως, στα περισσότερα κέντρα με τη μέθοδο της υαλοποίησης.
Μόλις η γυναίκα αποφασίσει να προσπαθήσει να μείνει έγκυος -αυτό μπορεί να είναι μήνες ή χρόνια αργότερα- τα ωάρια αποψύχονται, εγχέονται με ένα σπερματοζωάριο και αφήνονται σε έναν επωαστήρα να γονιμοποιηθούν. Μετά από δύο έως πέντε ημέρες, τα προκύπτοντα έμβρυα μεταφέρονται στη μήτρα με ένα λεπτό καθετήρα.
Θα πρέπει να αναφερθεί ότι κάποιες γυναίκες που έχουν λίγα ωάρια μπορεί να χρειαστεί να υποβληθούν σε πολλούς κύκλους διέγερσης, προκειμένου να έχουν έναν καλό αριθμό κατεψυγμένων ωαρίων (ο ιδανικός αριθμός είναι περίπου 20 – 30).
Ηλικιακά ζητήματα …
Ποια είναι η ιδανική ηλικία για να παγώσω τα ωάριά μου;
Από βιολογική απόψη, η απάντηση είναι απλή: όσο νεότερη, τόσο καλύτερα. Και αυτό για τον εξής λόγο: μια γυναίκα στα 20 της αναμένεται να έχει 15 με 25 ωάρια για κατάψυξη. Δεδομένου ότι τα ωάρια είναι καλής ποιότητας, θα χρειαστούν περίπου 4-5 ωάρια για να αποκτήσει ένα μωρό (μερικά δεν θα επιβιώσουν τη διαδικασία της απόψυξης, άλλα δεν θα γονιμοποιηθούν και άλλα θα παράγουν ανώμαλα έμβρυα). Μια γυναίκα 40 ετών, όμως, θα έχει στην καλύτερη των περιπτώσεων 8-10 ωάρια, ενώ μπορεί να χρειαστούν 25 ωάρια για να προκύπτει μια εγκυμοσύνη, επειδή τα ωάρια είναι κατώτερης ποιότητας…
Αλλά σε ποια ηλικία θα πρέπει μια γυναίκα να πάρει την απόφαση να παγώσει τα ωάριά της; Αυτό το ερώτημα είναι πολύ πιο δύσκολο να απαντηθεί. Η λειτουργία των ωοθηκών δεν είναι ίδια για κάθε γυναίκα. Ενώ ορισμένες γυναίκες 30 χρονών έχουν ήδη μειωμένη ωοθηκική λειτουργία, άλλες στα 40 τους έχουν εξαιρετικά ορμονικά επίπεδα … Ένα ιδανικό χρονικό πλαίσιο θα ήταν μεταξύ 30 και 35 χρονών, αλλά και πάλι, θα πρέπει να είμαστε προσεκτικοί καθώς αυτό μπορεί να μην ισχύει για όλες τις γυναίκες.
Ως οδηγός για το πότε θα πρέπει μια γυναίκα να παγώσει τα ωάριά της, μερικοί ειδικοί προτείνουν να μετρηθεί τακτικά μια ορμόνη στο αίμα που ονομάζεται Anti Mullerian Hormone (ΑΜΗ), η οποία είναι πολύ αξιόπιστη για να δείξει πώς λειτουργούν οι ωοθήκες και πως είναι το “απόθεμα” τους.
Ποιο είναι το ανώτερο όριο ηλικίας για να παγώσω τα ωάριά μου;
Σύμφωνα με την ESHRE, η κρυοσυντήρηση για γυναίκες άνω των 38 ετών δεν θα πρέπει να συνιστάται, εκτός εάν η εκτίμηση του ωοθηκικού αποθέματος δικαιολογεί την διαδικασία. Σε πολλά κέντρα εξωσωματικής γονιμοποίησης, το ανώτατο όριο είναι τα 43 έτη, γιατί σε αυτή την ηλικία τα ποσοστά εγκυμοσύνης μειώνονται δραματικά. Και πάλι, μπορεί να υπάρχουν εξαιρέσεις ανάλογα με την ωοθηκική λειτουργία κάθε γυναίκας.
Ποιο είναι το ανώτερο όριο ηλικίας για να χρησιμοποιήσω των παγωμένα ωάρια;
Όπως αναφέρθηκε πριν, η μήτρα “δεν γερνάει”. Υπάρχουν αναφορές για γυναίκες που έχουν γεννήσει ένα παιδί -με δωρεά ωαρίων από νεότερη γυναίκα- στα 60 τους. Αλλά υπάρχει ένα όριο όπου η εγκυμοσύνη δεν θα ωφελήσει ούτε τη γυναίκα, ούτε το παιδί της. Η ASRM συμβουλεύει κατά την εμβρυομεταφορά σε γυναίκες άνω των 55 ετών, επειδή πάνω από αυτή την ηλικία υπάρχει μεγαλύτερος κίνδυνος για τη γυναίκα και για το έμβρυο. Πολλά κέντρα στο εξωτερικό θέτουν ως όριο τα 50 έτη. Στην Ελλάδα, βάση νόμου, το όριο ηλικίας για έμβρυο μεταφορά, είτε με φρέσκα ή με κατεψυγμένα ωάρια είναι 50 ετών.
Πόσο αποτελεσματική είναι η κατάψυξη ωαρίων;
Από όλα τα κατεψυγμένα ωάρια, περίπου το 90-95% θα επιβιώσει την διαδικασία της απόψυξης. Όταν αυτά τα ωάρια γονιμοποιούνται, τα αποτελέσματα είναι συγκρίσιμα με εκείνα της εξωσωματικής γονιμοποίησης χρησιμοποιώντας φρέσκα ωάρια: 36-65% ποσοστό εγκυμοσύνης, ανάλογα με διάφορες μελέτες. Όπως και με την εξωσωματική γονιμοποίηση, τα ποσοστά επιτυχίας είναι καθαρά συνδεδεμένα με την ηλικία της μητέρας τη στιγμή της κατάψυξης: όσο νεότερη η γυναίκα, τόσο υψηλότερο το ποσοστό εγκυμοσύνης.
Τα αποτελέσματα αυτά, αν και εντυπωσιακά, δείχνουν ότι η κατάψυξη ωαρίων δεν είναι μια εγγύηση 100% επιτυχίας: από όλες τις γυναίκες που παγώνουν τα ωάριά τους, περίπου οι μισές από αυτές θα μείνουν έγκυες.
Πόσο καιρό μπορεί τα ωάρια να παραμένουν κατεψυγμένα;
Η κατάψυξη ωαρίων είναι μια σχετικά πρόσφατη διαδικασία, αλλά η πρακτική της κατάψυξης εμβρύων γίνεται εδώ και πολλά χρόνια, και έχουν επιτευχθεί εγκυμοσύνες με έμβρυα που ήταν κατεψυγμένα για περισσότερο από 20 χρόνια. Γι ‘αυτό αναμένουμε ότι, κατά πάσα πιθανότητα, το ίδιο θα ισχύει και για τα κατεψυγμένα ωάρια.
Είναι η κατάψυξη ωαρίων ασφαλής…
… Για τη γυναίκα;
Η κατάψυξη ωαρίων είναι μια πολύ ασφαλής διαδικασία, αν και όχι εντελώς ακίνδυνη. Τα φάρμακα που λαμβάνονται για τη διέγερση των ωοθηκών, η αναρρόφηση των ωαρίων και η αναισθησία που απαιτείται είναι πιθανές πηγές επιπλοκών. Εν συντομία, οι παρενέργειες των φαρμάκων είναι συνήθως ήπιες, καθώς μία από τις πιο επίφοβες επιπλοκές στην υποβοηθούμενη αναπαραγωγή, το σύνδρομο υπερδιέγερσης των ωοθηκών, είναι πολύ σπάνιο (επειδή η εμβρυομεταφορά γίνεται σε δεύτερο χρόνο). Οι υπόλοιποι κίνδυνοι εκτιμώνται ως εξής: κίνδυνοι από την αναισθησία: 1 / 10.000, κίνδυνος σοβαρής αιμορραγίας από τη ωοληψία: 1 / 2.500, κίνδυνο μόλυνσης: λιγότερο από 1/500. Για μια πιο λεπτομερής ανάλυση των επιπλοκών, διάβασε εδώ.
… Για το μωρό;
Μέχρι σήμερα, περισσότερα από 5.000 παιδιά έχουν γεννηθεί από κατεψυγμένα ωάρια, και τα διαθέσιμα δεδομένα φαίνεται να είναι καθησυχαστικά. Στη μεγαλύτερη μελέτη μέχρι στιγμής σε αυτό το θέμα παρακολούθησαν 900 μωρά, και το ποσοστό γενετικών ανωμαλιών ήταν ίδιο σε σχέση με το γενικό πληθυσμό. Φυσικά, δεδομένου ότι η κατάψυξη ωαρίων είναι μια σχετικά πρόσφατη διαδικασία, θα χρειαστούν πολλά χρόνια παρακολούθησης για την επιβεβαίωση της ασφάλειάς της.
Αναπάντητα ερωτήματα …
Υπάρχουν ακόμα πολλά αμφιλεγόμενα ζητήματα γύρω από την κατάψυξη ωαρίων: κάποιες γυναίκες πιστεύουν πως είναι “επαναστατική και απελευθερωτική, όπως το αντισυλληπτικό χάπι”, άλλες θεωρούν ότι είναι απλώς μέρος μιας κερδοφόρας επιχείρησης, που προσπαθεί να πείσει τις γυναίκες ότι επιβάλλεται να παγώσουν τα ωάρια τους και ότι είναι “ανεύθυνο” να μην το κάνουν. Η απόφαση των εταιριών Apple και Facebook να πληρώσουν αυτή τη διαδικασία στις υπαλλήλους τους “φούντωσε” ακόμα περισσότερο τη διαμάχη…
Προς το παρόν, παραμένουν ορισμένα ερωτήματα να απαντηθούν:
• Θα γίνει η κατάψυξη ωαρίων μια διαδικασία ρουτίνας, ένα είδος “ασφάλειας” που θα έχει κάθε γυναίκα;
• Θα ωθήσει τις γυναίκες να γίνονται μητέρες σε μεγαλύτερη ηλικία, με αποτέλεσμα να δημιουργήσει μια γενιά ηλικιωμένων γονέων;
• Είναι η κατάψυξη ωαρίων το μέλλον της γονιμότητας; Θα συμβάλει στην “ιατρικοποίηση” της διαδικασίας σύλληψης;
• Μπορούμε / Επιτρέπεται να ξεγελάσουμε το βιολογικό μας ρολόι;
• Μήπως η μεγάλες εταιρείες θα αναγκάζουν τις γυναίκες να αφιερώσουν τη ζωή τους στην δουλειά τους, για να τις «ξεφορτωθούν» στα 50 τους; Μήπως οι προσπάθειες των γυναικών θα πρέπει να επικεντρωθούν περισσότερο στην επίτευξη μεγαλύτερων προνομίων για τις εργαζόμενες μητέρες, παρά στο να τους πληρώσουν την κατάψυξη ωαρίων;
• Τι θα συμβεί με όλα τα κατεψυγμένα, αχρησιμοποίητα ωάρια;
• Ποιες είναι οι ψυχολογικές επιπτώσεις της κατάψυξης ωαρίων, ιδίως στις γυναίκες που πάγωσαν τα ωάριά τους, αλλά τελικά η διαδικασία απέτυχε και δεν μείνανε έγκυες;
Συμπεράσματα…
Η κατάψυξη ωαρίων δεν είναι εγγύηση για μια μελλοντική εγκυμοσύνη. Αν καθυστερείς την τεκνοποίηση υπάρχει ενδεχόμενο να χάσεις την ευκαιρία να κάνεις ένα παιδί.- Η διαδικασία αυτή θα πρέπει να θεωρηθεί ως το «σχέδιο Β»: ένα μέτρο έκτακτης ανάγκης σε περίπτωση που φοβάσαι ότι δεν θα είσαι σε θέση να κάνεις παιδιά πριν σου τελειώσουν τα ωάρια.
- Προτού αποφασίσεις να παγώσεις τα ωάριά σου, θα πρέπει να συζητήσεις εκτενώς τη διαδικασία με έναν εξειδικευμένο επαγγελματία, προκειμένου να μάθεις τους κινδύνους και τις πιθανότητες επιτυχίας στη συγκεκριμένη περίπτωσή σου.
- Και το βασικότερο από όλα, είναι πολύ σημαντικό να γνωρίζεις ότι στις γυναίκες, όσο μεγαλώνουμε, μειώνεται η γονιμότητα. Συνεπώς, εφόσον είναι δυνατόν, δεν θα πρέπει να καθυστερήσεις την τεκνοποίηση. Το βιολογικό μας ρολόι πράγματι χτυπά!
More info at gofertile.eu
Βιβλιογραφία
Egg Freezing for a Future Pregnancy: What to Know. WebMD
Φωτογραφίες
Intro: Getty images; oocyte: scitechdaily.com; career woman: youqueen.com; hormone injection: fssc.com.au; intra cytoplasmic sperm injection: Wellcome images, Flickr.com; ideal age: Tatyana A, Flickr.com; age limit to use frozen eggs ffemagazine.com; pregnant heart: Olivier Martins, Flickr.com; Egg freezing: midlandfertility.com; safety for the woman: theage.com.au; for the baby: Daniel James, Flickr.com; unanswered questions: Stefano Corso, Flickr.com; young pregnant woman: Tips Times Admin, Flickr.com.

Pingback: ΠΡΟΣΠΑΘΕΙΤΕ ΝΑ ΜΕΙΝΕΤΕ ΕΓΚΥΟΣ; 14 ΜΥΘΟΙ ΓΙΑ ΤΗΝ ΓΟΝΙΜΟΤΗΤΑ ΠΟΥ ΔΕΝ ΠΡΕΠΕΙ ΝΑ ΠΙΣΤΕΥΕΤΕ | Woman 2 women